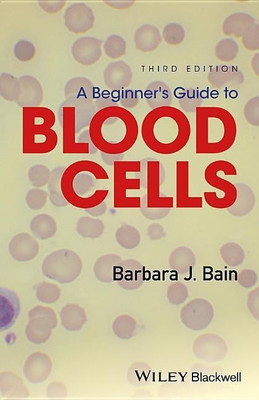

A Beginner's Guide to Blood Cells(English, Paperback, Bain Barbara J.)
Quick Overview
Product Price Comparison
The third edition of this popular pocket book, A Beginner's Guide to Blood Cells written by Professor Barbara Bain, provides a concise introduction to normal and abnormal blood cells and blood counts for trainees in haematology. Includes a brand new chapter on emergency morphology, designed to make the clinical significance and urgency of certain laboratory findings clear for biomedical scientists and to assist trainee haematologists in the recognition of major clinically important abnormalities Contains exceptional full colour images throughout Introduces important basic concepts of hematology, setting haematological findings in a clinical context Provides a fully updated self-assessment section An essential resource for trainee haematologists, biomedical scientists, and biomedical science and medical students